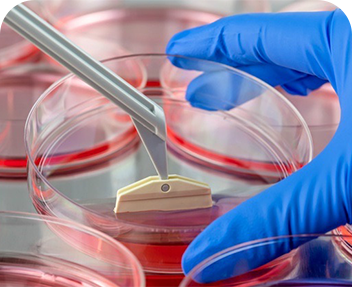

At Emmes Group, our work is driven by a simple but profound belief: truth matters. Since our founding in 1977, we’ve been committed to uncovering truth in clinical research – through scientific rigor, operational excellence, and deep collaboration with our clients and partners. That truth fuels better decisions, faster treatments, and more confident health outcomes.
News

History
Founded as Emmes more than 47 years ago, Emmes Group has grown to become one of the primary clinical research providers to the US government before expanding into public-private partnerships and commercial biopharma.

Leadership
We are led by a dynamic team of visionaries who bring a wealth of experience, expertise and passion to drive our mission.